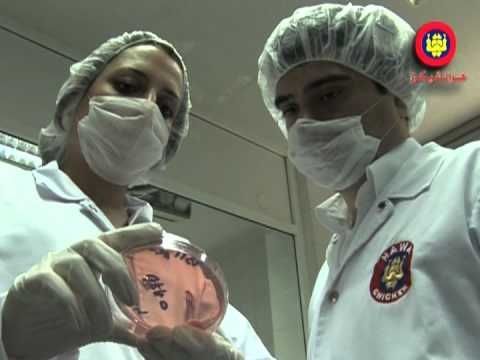

حقّقت العلامات التجارية اللبنانية ولا تزال، نجاحات تشهد لها الأسواق الداخلية المحلية كما اكتسبت ثقة وسمعة المستهلكين والأسواق الإقليمية وحتى العالمية منها.
من النجاحات اللافتة التي رسمت خطاً بيانياً متصاعداً شركة "هواتشيكن" للصناعات الغذائية التي بدأت مسيرتها منذ عام 1957 وهي مستمرّة بثبات وتقدّم مُبرمج وملحوظ. تميّزت في قطاعها، وتمكّنت من الإستحواذ على أسواق مكنتها من تنويع انتاجها المواكب للتطوّر ودخلت أصنافها اللبنانية إلى كل بيت في لبنان والدول العربية إلى أن أصبح اسم "هواتشيكن" معياراً للجودة وضمانة السلامة الغذائية، ما انعكس نجاحاً أهّلها لتتصدّر المركز الأول في لبنان والشرق الأوسط.
ويتضح هذا التطور، ضمن سلسلة متكاملة في مجال إنتاج وتربية وتصنيع وتوزيع "الفروج"، حيث تتعدّد أصناف "هواتشيكن" المتنوّعة، والتي باتت معروفة ومطلوبة على كل مائدة، والمطلوب الحفاظ على هذه الثقة التي كانت ركيزة المؤسسة اللبنانية لانتشارها عربياً حيث تنتشر أصناف "هواتشيكن" ضمن خطة تسويقية مدروسة أكسبتها الريادة في لبنان والأسواق العربية والعالمية.
حصلت "هواتشيكن" بجدارة على جوائز محلية وعالمية عديدة، كثمرة لانتشارها وانتاجها، وللمجهود والكفاح على مدى أكثر من خمسين عاماً، وباتت من كبرى المؤسسات اللبنانية في قطاع الدواجن، التي تضم أكثر من ألف مستخدم موزّعين بين إداريين وأجراء وتغطي أكثر من 20% من نسبة احتياجات السوق الإستهلاكية، وتتميّز باعتمادها دائماً في عملها على أحدث المعايير العالمية للحفاظ على جودة ونوعية انتاجها.
لا شك أنّ الإنجازات التي حققتها "هواتشيكن" تعود لحكمة إدارتها وعلى رأسها الدكتور جان الهوا رئيس مجلس الإدارة، المدير العام، ذو الخبرة الطويلة المدعمة بالتطور التكنولوجي، ما أهّله ليرأس النقابة اللبنانية للدواجن، ويدير القطاع وفق معايير السلامة الغذائية العالمية.
لم يقتصر عمل جان الهوا المهني، بل تخطّاه وفق قناعاته الى واجبات إنسانية تجاه المجتمع اللبناني، وتعدّدت مساهماته ومساعداته في دعم الشباب على اكتساب العلم، بالإضافة إلى دعم العديد من الجمعيات والنوادي والبرامج التي تُعنى بتأهيل جيل واعد من الشباب.
"هواتشيكن" علامة تجارية نفتخر بها في لبنان لأنّها أثبتت أنّها الاولى بسبب التقنيات الموجودة في مزارعها كما ان النظافة هي عامل مهمّ لنجاح هذه المؤسسة المهمة التي تقدّم لنا أجود انواع الدجاج .

تعليقات الزوار